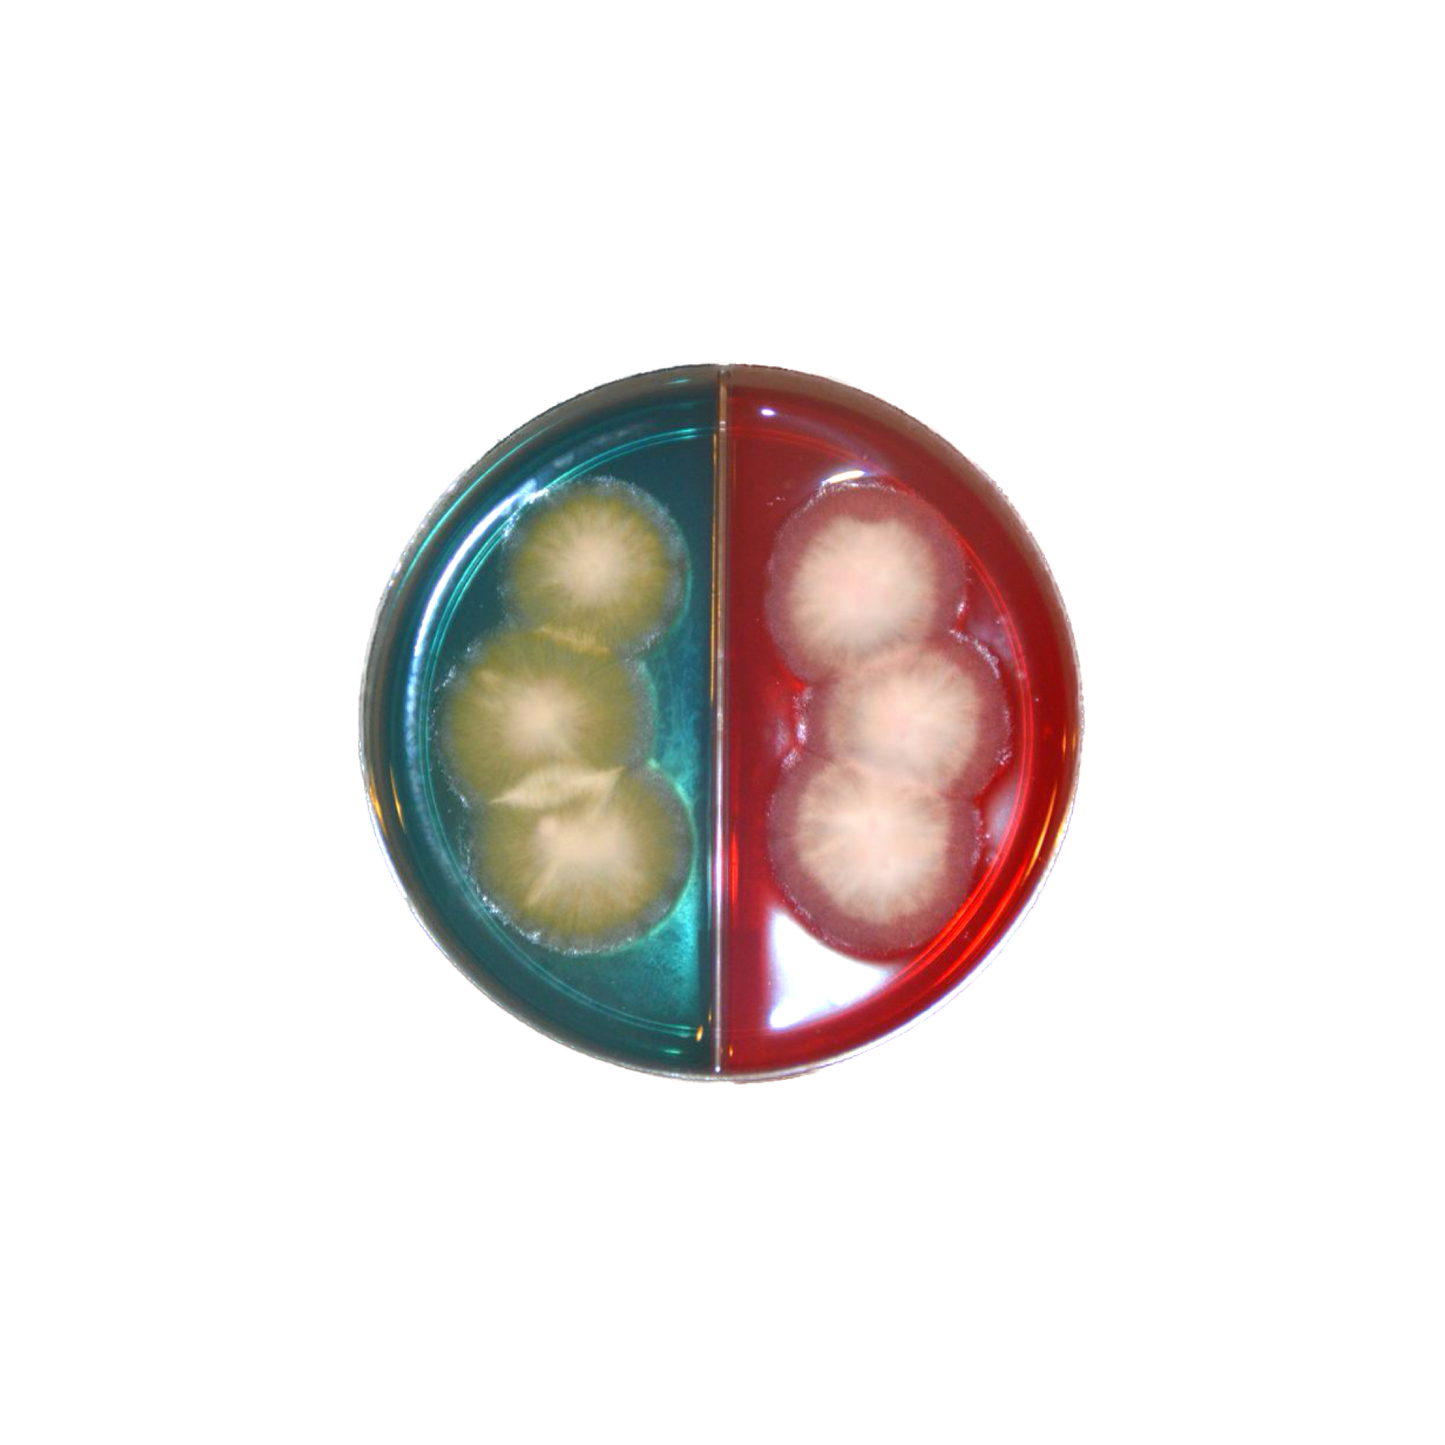
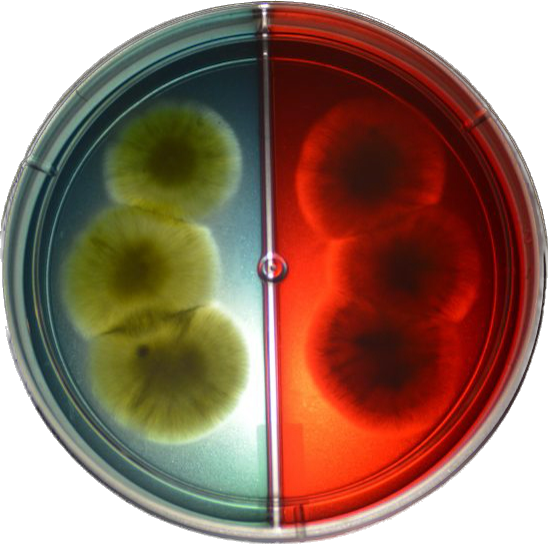
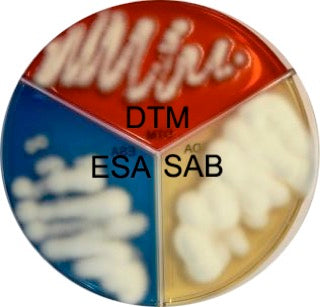

1
/
van
10
VetRed
ChroMyco® Duo Dermatophyte Test System
ChroMyco® Duo Dermatophyte Test System
Normale prijs
€30,00 EUR
Normale prijs
Aanbiedingsprijs
€30,00 EUR
Eenheidsprijs
/
per
In stock
Kan beschikbaarheid voor afhalen niet laden
ChroMyco® Duo Dermatofyten testsysteem
Mogelijk bent u bekend met DTM (Dermatofyten Test Medium) voor de detectie van dermatofyten. We hebben een medium toegevoegd, dat we ESA (Enhanced Sporulation Agar) noemden. Ons nieuwe medium geeft een overvloedige groei, met sterke pigmentatie en sporulatie, waardoor exacte determinatie mogelijk is, en is minder vatbaar voor vals-positieve kleurveranderingen, zoals te zien is bij DTM.
Voordelen :
- dubbele kans om het goed te doen!
- gemakkelijke inenting op deze plaat
- op ESA sterke pigmentatie en sporulatie
- eenvoudig een (Sellotape) monster nemen
-hele bord kan ter beoordeling door deskundige opgestuurd worden (UN3373!)
- ESA-cultuur kan meteen worden gebruikt voor microscopie
- indien dermatofyt: kleur verandert snel op ESA
- DTM alleen kan vals-positieve kleurveranderingen veroorzaken
REFERENTIES
1. Taplin, D., Zaias, N. Rebell, G., en Blank, H. 1969. Isolatie en herkenning van dermatofyten op een nieuw medium (DTM). Boog. Derm.; 99:203-209.
2. Rinaldi, MG, Stevens, VJ, en Halde, C. 1973. Een nieuw sporulatiemedium voor primaire isolatie en identificatie van dermatofyten. Abs: AmerSoc. Micro. Ontmoeting, Miami.
3. Zaias, N., Taplin, D. 1966. Verbeterde voorbereiding voor de diagnose van mycologische ziekten. Boog. Derm.; 93:608-609.
4. Rebell, G. en Taplin, D. 1974. Dermatofyten. Hun herkenning en identificatie. U. Miami Press, Coral Gables, Fl. Fijne kleurenfoto's.
5. Muller, GH en Kirk, RW 1966. Dermatologie van kleine dieren. WB Saunders Co., Philadelphia.
Deel